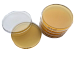
Контактные чашки Петри 90 мм с триптон-соевым агаром с лецитином, гистидином и тиосульфатом натрия, Tween 80, Россия

Готовые к применению питательные среды, предназначенные для мониторинга микробной чистоты поверхностей в изоляторах и чистых производственных зонах, подвергаются стерилизации гамма-излючением и поставляются в тройной упаковке.
Особенности готовой среды
- Внешний слой, имеет перфорированную вставку для контроля влажности, а также индикаторы парофазного пероксида водорода VHP (Vaporized Hydrogen Peroxid) и стерильности. Индикатор VHP сигнализирует о герметичности запайки двух внутренних слоев и отсутствии контакта с рабочим раствором. Изменение цвета индикатора свидетельствует о проникновении H₂O₂ внутрь и непригодности среды к дальнейшему применению.
- Средний слой, являющийся VHP-барьерным, с прикрепленным к внутренней стороне гелевым пакетиком. Этот слой обеспечивает защиту при обработке продукции, поступающей в рабочую зону.
- Внутренний слой, гарантирующий стерильность питательной среды и самой чашки. Перед применением снимается внешний слой, чашки помещаются в перегрузочное окно производственной лаборатории, проходят VHP-обработку, после чего удаляется средний слой и чашки готовы к использованию.
Конструкция чашек Петри, с выпуклой поверхностью агара, обеспечивает оптимальный контакт с анализируемой поверхностью.
Надежно фиксирующаяся крышка предотвращает случайное открытие после взятия пробы.
Для упрощения подсчета колоний на дно чашки нанесена разметка в виде сетки.